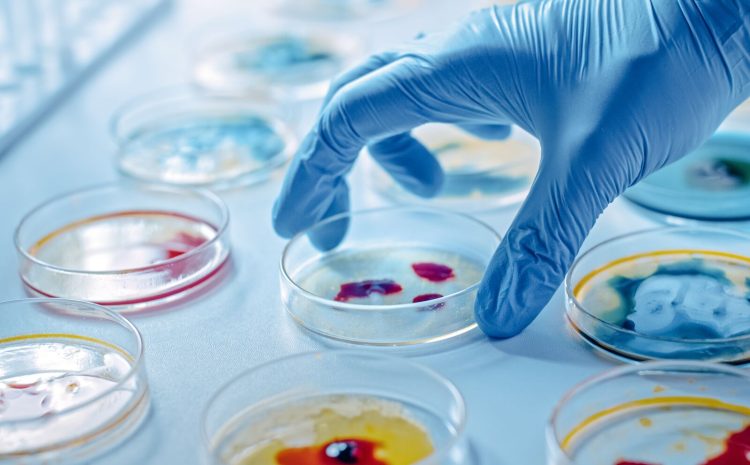
microbiology

Funder: CDC Ethiopia
General Objective:
The aim was to enhance the quality of microbiology laboratory services in selected health institutions of Addis Ababa from January 2015 to March 2016.
Enhancing Microbiology Laboratory Services
Specific Objectives:
- To strengthen the capacity of microbiology laboratories in the selected health institutions.
- To implement a Laboratory Quality Management System (LQMS) in the microbiology laboratories.
- To upgrade the microbiology laboratory services provided in the selected health institutions.
Project Area: Addis Ababa
Project Sites:
- Yekatit 12 Hospital Medical College (Y12H/LMC)
- All African Leprosy, Tuberculosis, Rehabilitation and Training Centre (ALERT Centre)
- Tikur Anbesa Specialized Hospital (TASH)
- Public Health Research Emergency Control (PHREC)
- ARSHO Diagnostics
Mentors:
- Dr. Yimtubeznash Woldeamanuel (Addis Ababa University)
- Dr. Tsehaynesh Lema (AHRI)
- Mr. Ayelign Derebe (Yekatit 12 Hospital)
- Dr. Rajiha Abubeker (EPHI)
- Dr. Yohannes W/Kidan (AAHB)
Expert Laboratory Guidance
Our advisory services are built on years of field experience and deep technical knowledge. We work closely with stakeholders to ensure laboratory systems are not only high-performing but also fully integrated into the broader public health strategy for disease control and surveillance.





